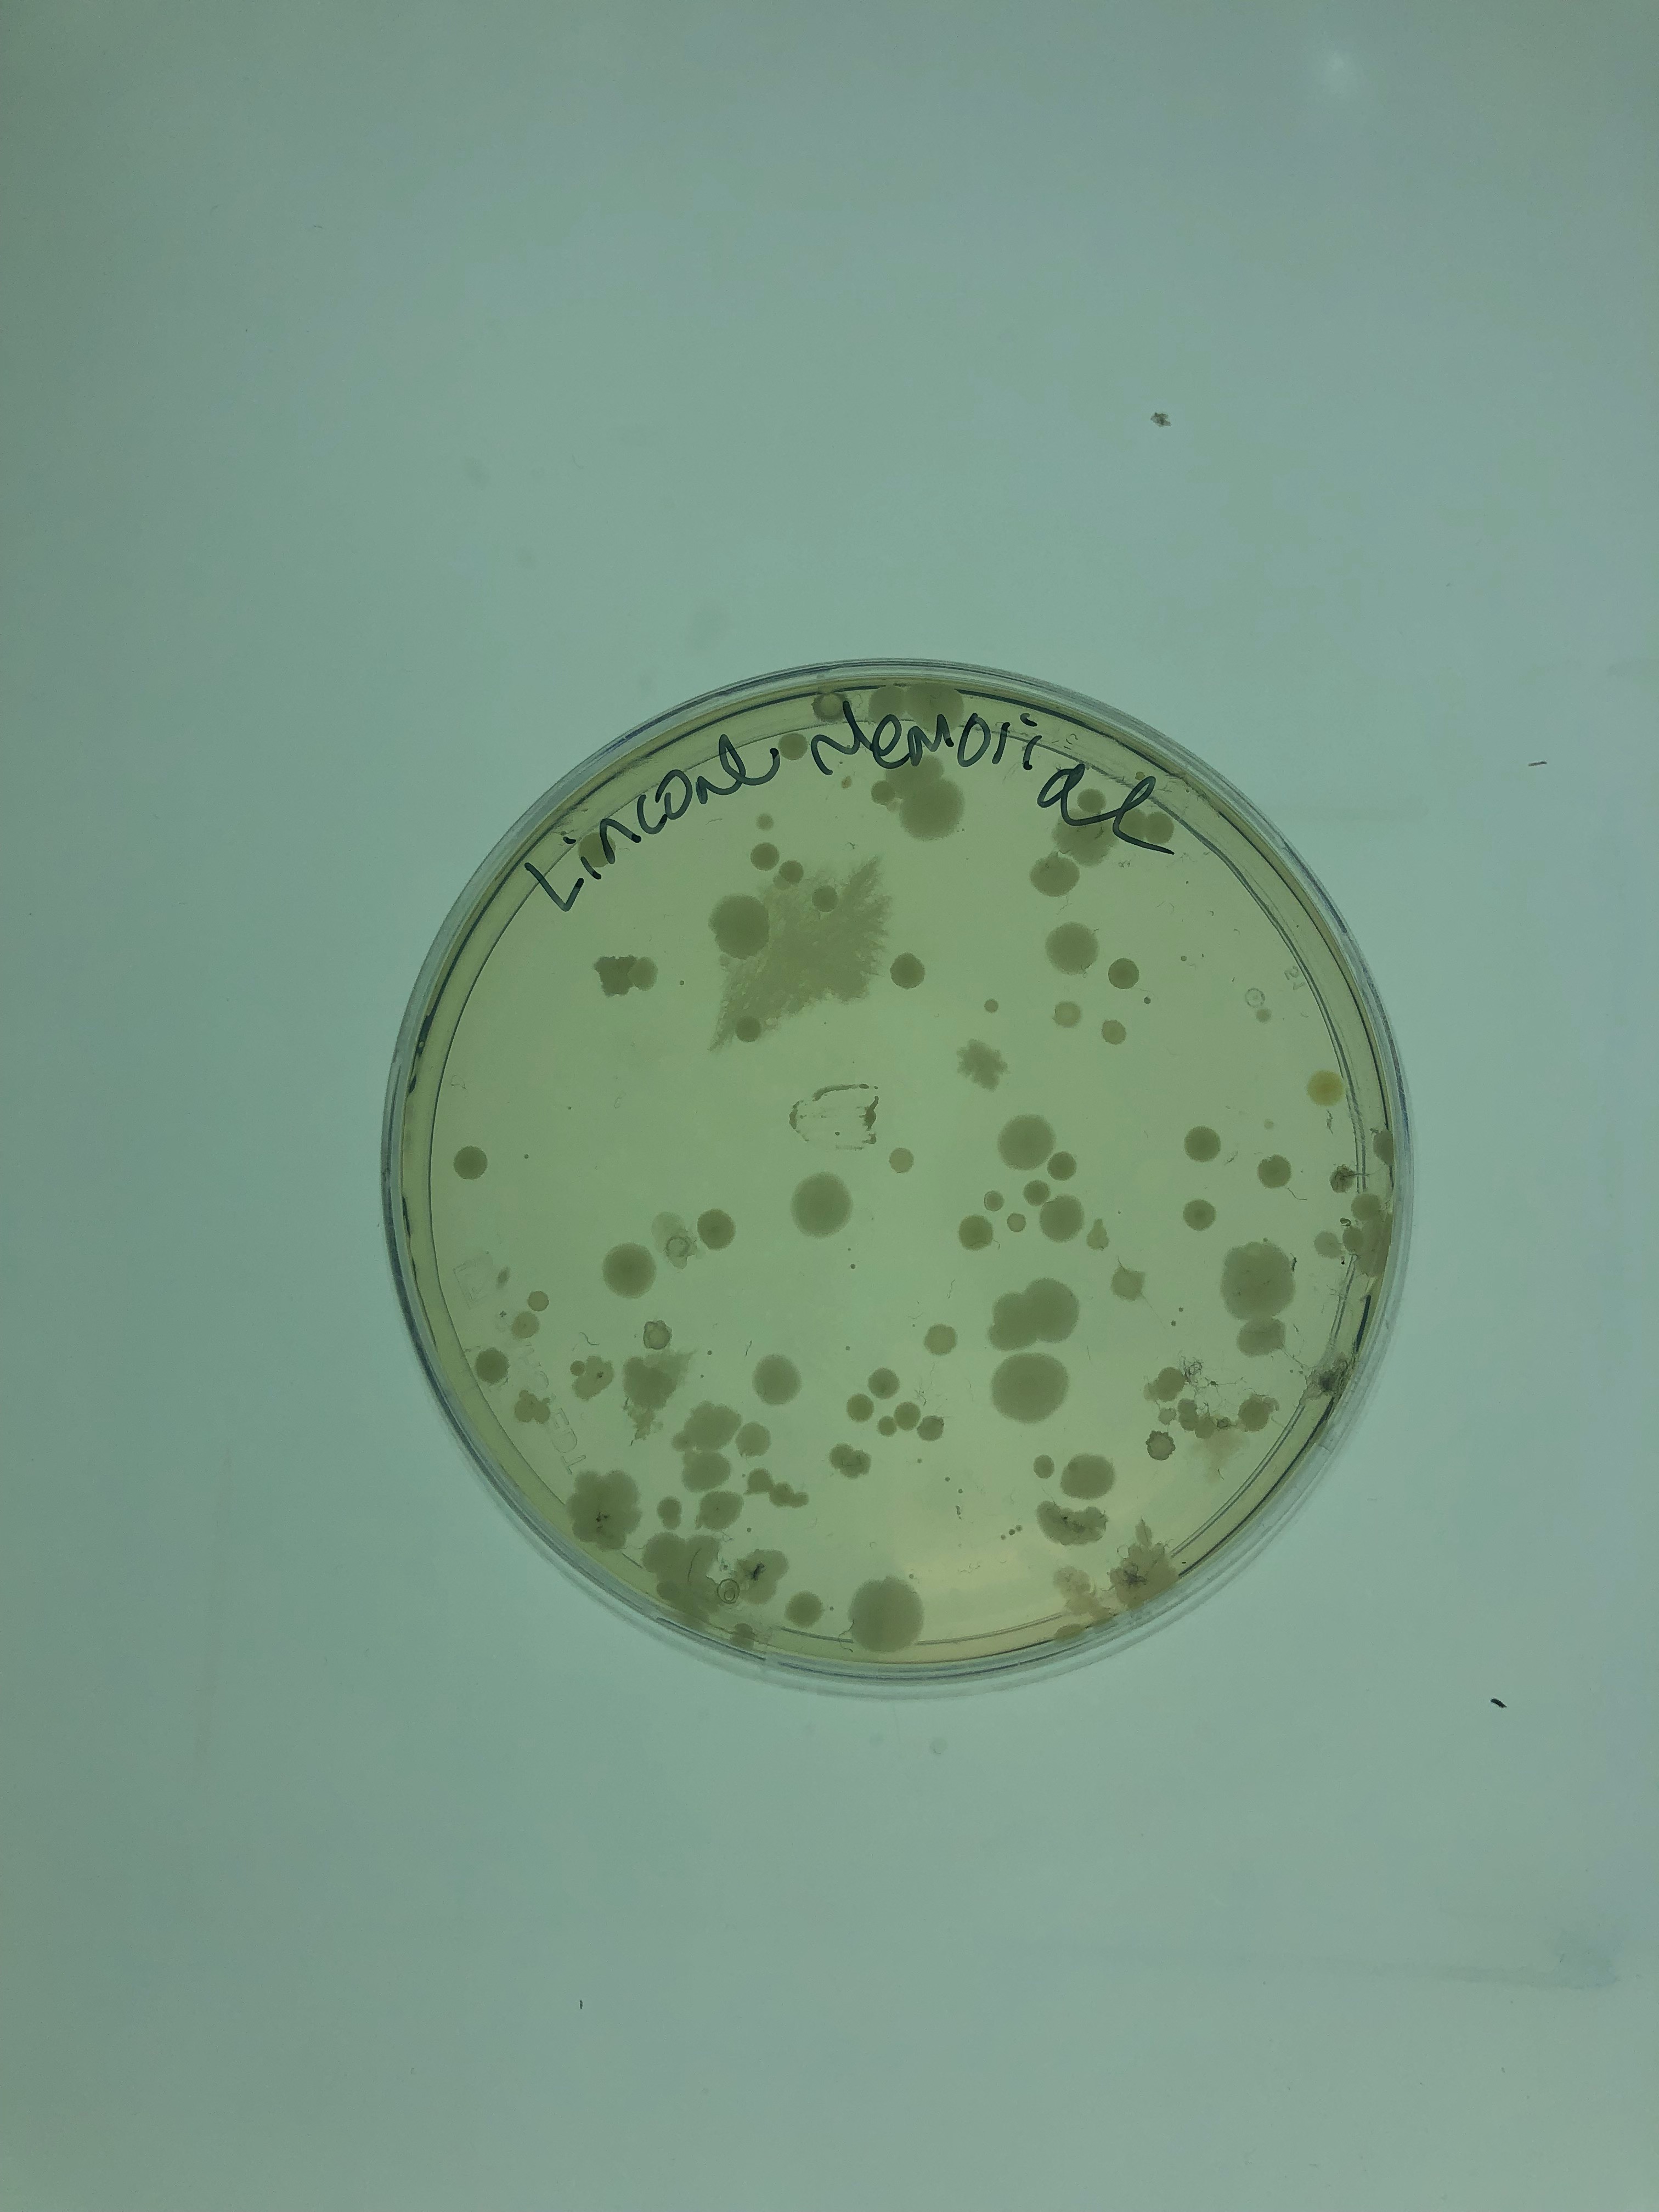
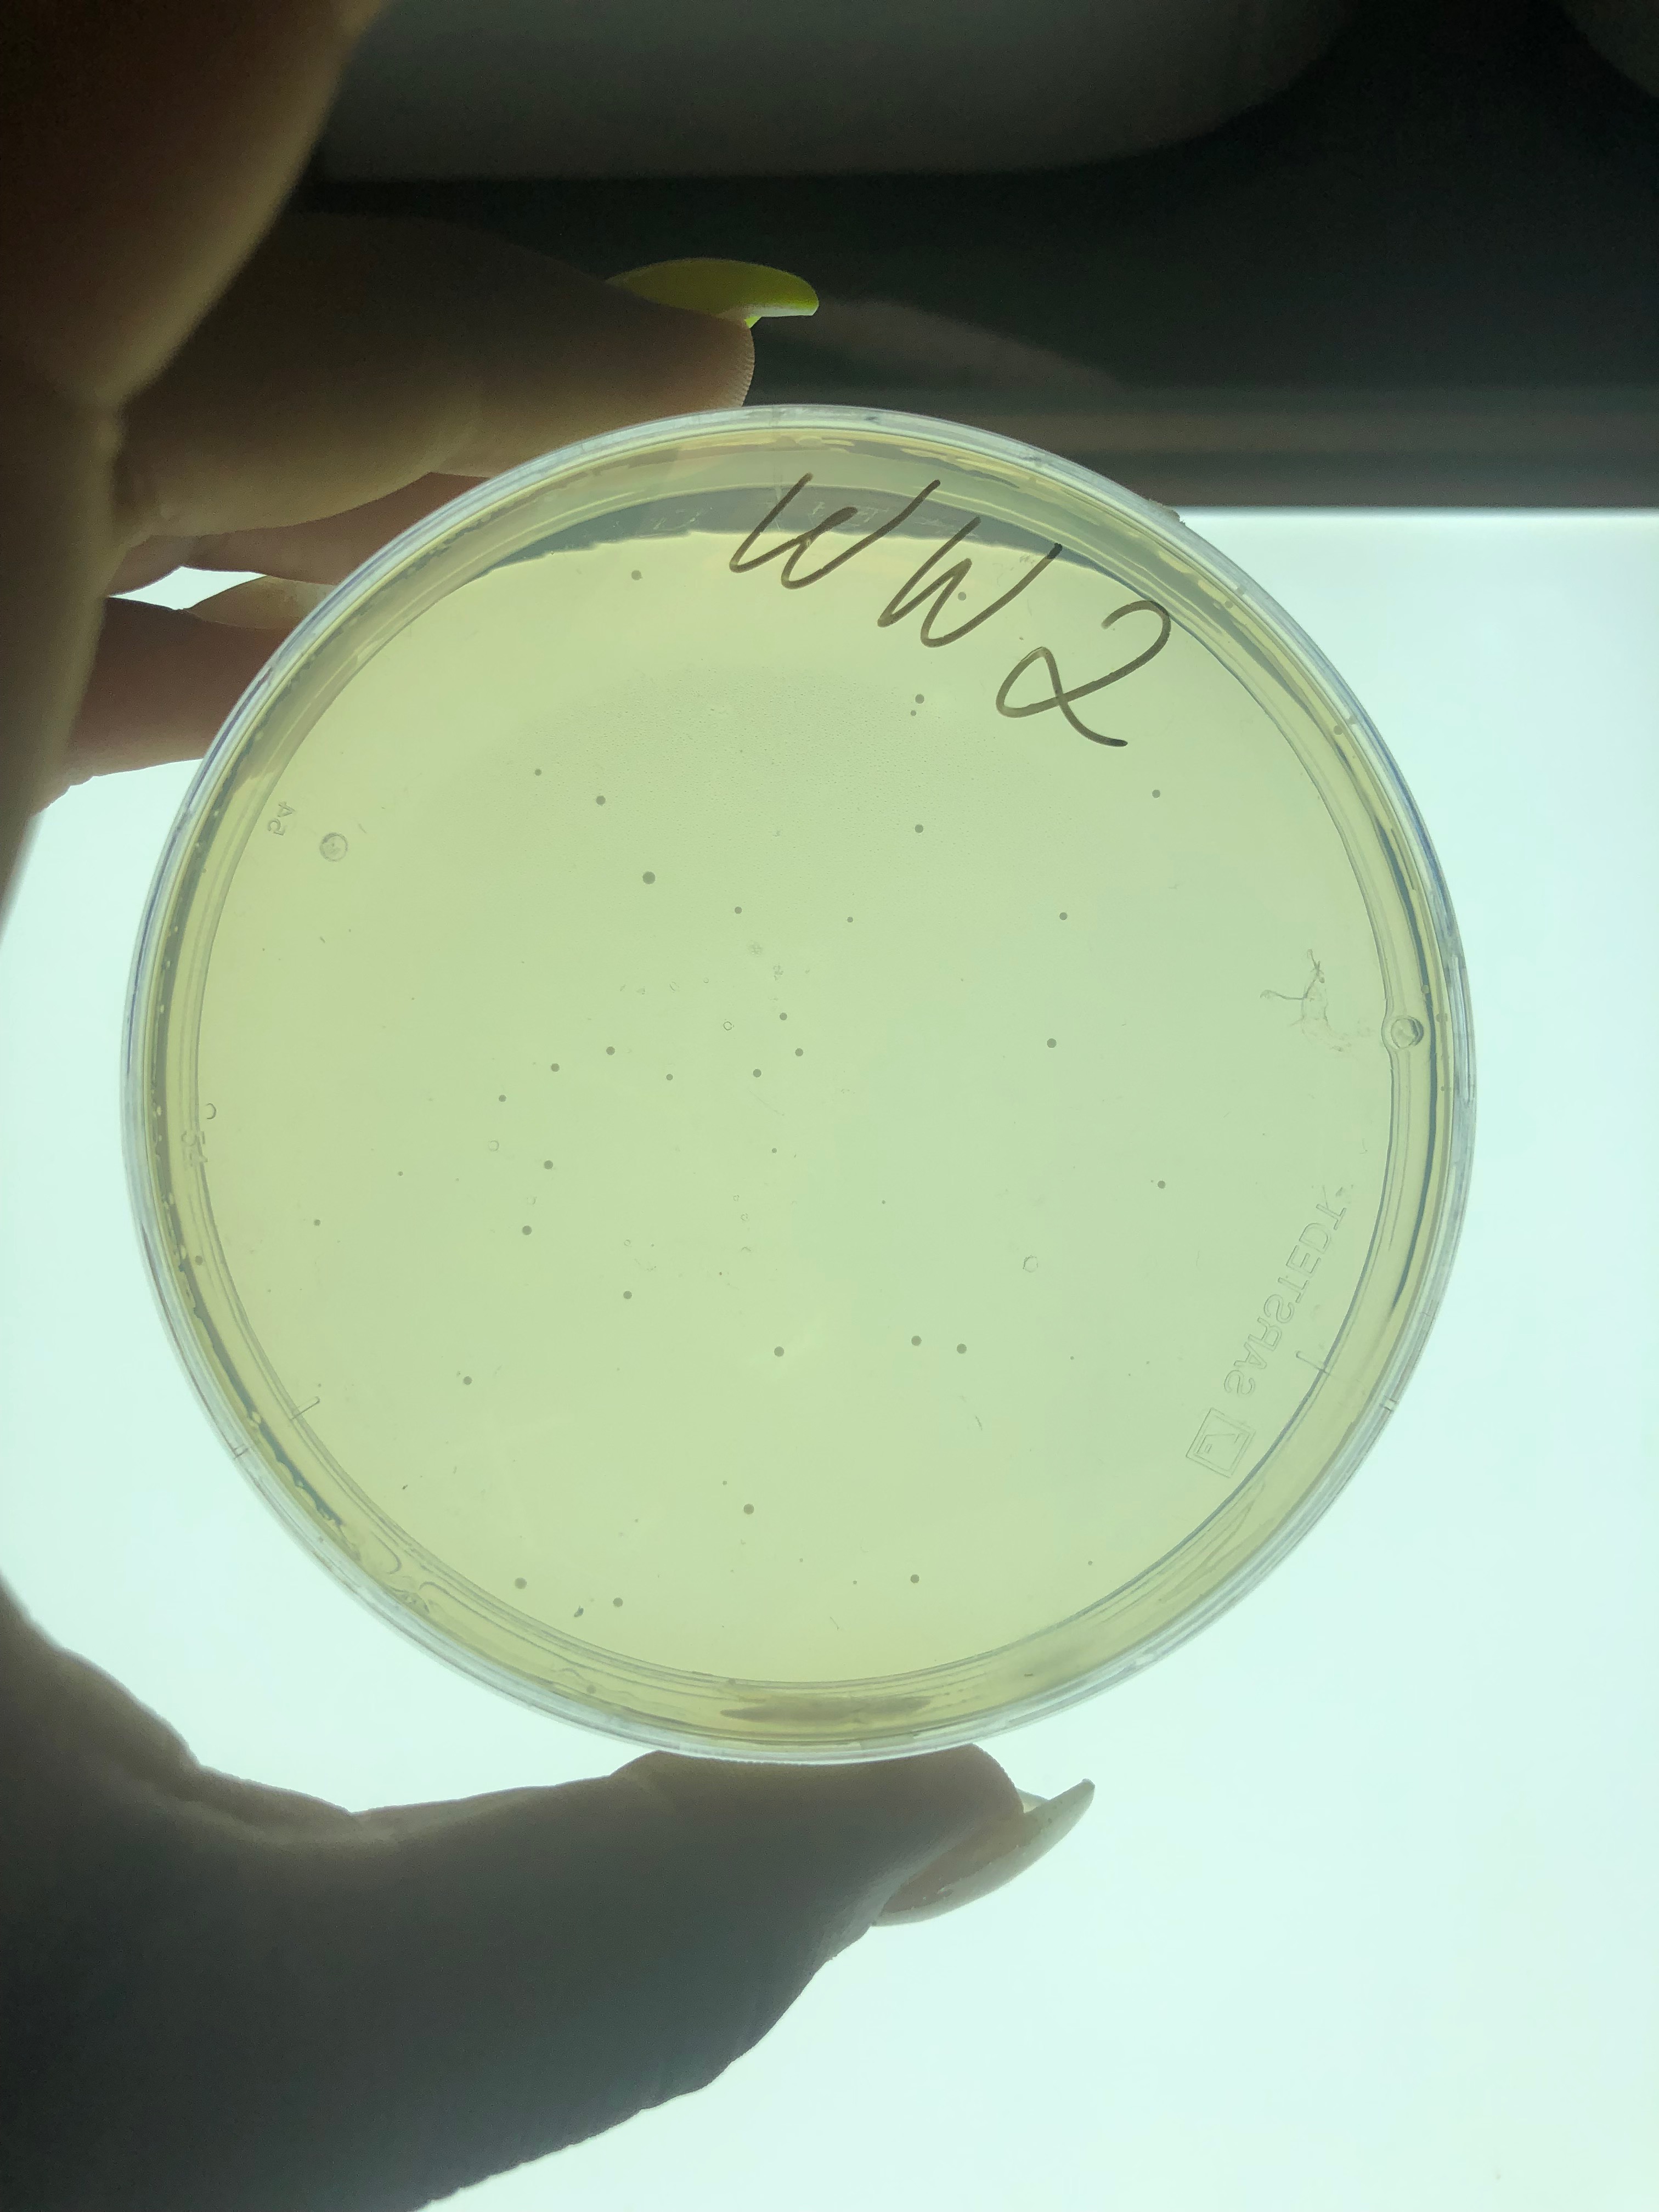

This past week a few lab members and summer interns headed down to the national mall to test out kit S-30 in a unique place. Under the sweltering heat, interns collected bacterial swabs and water samples of various fountains and statues. The trip started with a visit to the Lincoln Memorial and it’s iconic stairs.

Following the stairs, a sample of water was taken from the reflecting pool. After collecting these samples, the group stopped by to see Albert Einstein and Martin Luther King Jr.’s statues. Both of the sculptures produced plates full of bacteria! Directly below is a picture of bacteria from the Lincoln Memorial.
Additional water samples were taken from the WWII memorial fountain and the Tidal Basin. Surprisingly the WWII fountain plate did not grow much bacteria. Below is a picture of the Martin Luther King Jr. plate.

The above plate is a picture of the WWII fountain water which proved to be almost bacteria free.
After growing our monumental bacteria on agar plates we selected individual colonies to gram stain. Below is a gram stain from the Lincoln Memorial which looks to be very gram positive and a gram stain from the tidal basin which is gram negative. Gram staining also revealed microbes in the WWII fountains that were not apparent on our agar plate.



And lastly the key to the match up game from Monday is 1-E, 2-B, 3-D, 4-A, 5-C.
Happy microbial searching, hot weather vacationing, and summer scienceing!

